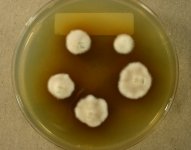

<< back to search
IMAGES:

Search Details
add to cart
| UAMH Number: | 6060 |
|---|---|
| Species Name: | Suillus tomentosus |
| Type: | |
| Synonyms: | Boletus tomentosus |
| Taxonomy: | FUNGI Basidiomycota, Agaricomycetes, Boletales, Suillaceae |
| Strain History: | Hutchison, L.J. (LH-18-87) -> UAMH |
| Substrate: | scattered/gregarious in needle litter below Pinus banksiana | Location: | CANADA Manitoba, Reynolds, Sandilands Provincial Forest (GEO: 49.399722,-96.035278) |
| Isolator: | L. Hutchison |
| Isolation Date: | 1987-08-27 |
| Date Received: | 1988-04-05 |
| Characters: | CULTURE CONDITIONS no clamps - fide UAMH 2011 // MYCORRHIZAE - // PIGMENT yellow - (Click for publications citing UAMH 6060) |
| Compounds: | |
| Cross Reference: | TRTC LH-18-87 |
| Collections: | Living Strains; Dried Herbarium Material |
| Pathogenic Potential: | Human: no | Animal: no | Plant: no |
| Biosafety Risk Group: | RG1 (check the PHAC ePATHogen Risk Group Database for updates) |
| Regulatory Requirements: | No restrictions for Canadian requesters. International requesters must provide all legally required importation documentation prior to shipment. Plant pathogenicity status may be verified by using the USDA Agricultural Research Service (ARS) Fungal Database |
| MycoBank ID: | 339870 |
IMAGES: